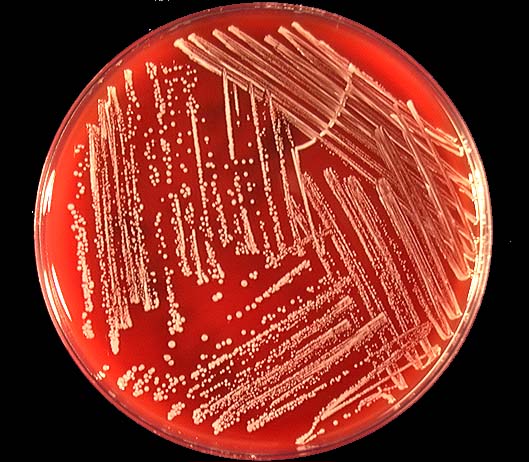

Kóagúlasa neikvæðir stafýlókokkar – duldi júgurbólguvaldurinn
Höfundur: Snorri Sigurðsson sns@seges.dk Sviðsstjóri mjólkurgæðasviðs Dýralækninga- og gæðadeild SEGES í Danmörku
Duldar júgurbólgusýkingar af völdum kóagúlasa neikvæðum stafýlókokkum, sem stundum eru nefndir K-, KNS eða CNS (erlendis), eru afar algengar víða um heim og eru þessar KNS sýkingar oftast flokkaðar í einn meðferðarflokk. Með því er átt við að þessir sýklar hafa verið meðhöndlaðir með sama hætti og oftast ráðlagt að meðhöndla kýr með dulda KNS sýkingu í geldstöðunni svo komast megi fyrir sýkinguna.
Gröftur úr alvarlega sýktu júgri.
Mynd / UGA
Þessir sýklar hafa oft verið flokkaðir einhvers staðar mitt á milli umhverfissýkla og smitandi sýkla en KNS er þó bara yfirheiti á stórum hópi ólíkra baktería. Þegar um annars konar sýkingar er að ræða, s.s. af völdum Aureus, E. coli eða Strep. uberis, setja mjólkurgæðaráðgjafar oftast upp sérstakar aðgerðaráætlanir í samráði við dýralækna og bændurna. Þá miða þessar sértæku áætlanir að því að koma í veg fyrir sýkingar. Þessar áætlanir geta verið mjög ólíkar á milli kúabúa, allt eftir því hvaða sýklar eru algengastir á viðkomandi kúabúi.
Þegar talið hefur hingað til borist að KNS sýkingum hafa ráðin þó oftast verið heldur knöpp og ekki verið gerðar jafn sérhæfðar áætlanir og þegar um annars konar sýkingar er að ræða. Nú kann þetta þó að vera að breytast en með tilkomu erfðaefnisgreiningar á KNS sýklum og þekkingar á hegðun einstakra undirhópa KNS, er nú stutt í að hægt verði að ná mun betri árangri en áður.
Bætt greiningartækni
Í dag er hægt að greina þessar bakteríur mun nánar en áður og þá hefur komið í ljós, líkt og með aðrar bakteríur, að beita þarf ólíkum vinnubrögðum eftir því hvaða undirflokkur KNS er að herja á kýrnar hverju sinni.
Í vísindaritinu Journal of Dairy Science var nýverið birt sérlega áhugaverð grein um ólíka undirflokka KNS en greinin byggði á niðurstöðum rannsóknar sem gerð var á 100 kúabúum í Hollandi og var markmið rannsóknarinnar að skoða áhrif fjósgerða og vinnubragða á tíðni ólíkra undirhópa KNS.
Kúabúin voru valin af handahófi úr skýrsluhaldsgrunni og í úrtakinu voru afar fjölbreytt fjós og misstór eða allt frá 92 þúsund lítra ársframleiðslu upp í 1,5 milljónir lítra og frá básafjósum upp í hringekjufjós og allt þar á milli. Rannsóknin fór þannig fram að þremur tankmjólkursýnum var safnað frá hverju búi á þriggja mánaða tímabili og auk þess fylltu hollensku bændurnir út eyðublað um vinnubrögð sín m.m. Sýnin voru svo erfðaefnisgreind með PCR tækni og niðurstöðurnar settar í samhengi við ofangreinda þætti.
Staf. equorum algengasti undirflokkur
Í niðurstöðunum kemur fram að oftast er um bakteríu að ræða sem heitir Staf. equorum, þá Staf. haemolyticus og síðan Staf. epidermidis en allar þessar bakteríur eru s.s. venjulega flokkaðar sem KNS. Þá kom fram í rannsókninni að það eru töluverðar árstíðarsveiflur á tíðni KNS undirflokka og fer það einnig eftir fjósgerðinni. Þannig er hlutfall Staf. epidermidis, Staf. simulans og Staf. cohni hærra í tanksýnum frá básafjósum og hálmdýnufjósum en í tankmjólk frá legubásafjósum.
Þekking okkar á þessum ólíku undirflokkum KNS er enn heldur takmörkuð en það mun breytast á komandi tímum og því er áhugavert að skoða nánar hvað hollenska vísindafólkið fann.
Vinnubrögðin skipta máli
Önnur áhugaverð staðreynd var að hlutfall ólíkra undirhópa KNS var verulega breytilegt eftir því hvernig vinnubrögðin voru á kúabúunum. Ef júgurhárin voru t.d. klippt reglulega snarminnkuðu líkurnar á því að Staf chromogenes, Staf. simulans og Staf. xylosus gætu fjölgað sér verulega, en þessar þrjár tegundir hafa áður verið sterkt tengdar við júgurbólgu.
Þá kom í ljós, e.t.v. nokkuð óvænt. Þau bú sem voru með í mánaðarlegri júgurheilbrigðisþjónustu dýralækna voru einnig líklegri til þess að hafa hærra hlutfall af þessum þremur undirflokkum KNS.
Þessar þrjár undirtegundir KNS hafa verið sterklega tengdar við háa frumutölu frá einstökum júgurhlutum og gæti þessi óvænta niðurstaða einfaldlega bent til þess að þau bú sem eru að kljást við júgurheilbrigðisvandamál séu einmitt líklegri til þess að kaupa sér reglubundna júgurheilbrigðisþjónustu. Þess vegna hafi einmitt þetta samhengi fundist.
Þau bú sem fá alltaf úrvalsmjólkurálag eða þau bú sem nota eitthvert sótthreinsandi efni á spenana fyrir mjaltir reyndust síður vera með Staf. equorum í tankmjólkursýnunum en þessi baktería kemur helst frá umhverfinu inn í mjólkina og hefur neikvæð áhrif á líftölu mjólkur. Bendir tilvist hennar til þess að vinnubrögðum við þrif og umhirðu sé ábótavant.
Á búum sem notuðu sömu tuskuna á fleiri en eina kú, við forþvott fyrir mjaltir, var mun hærra hlutfall af Staf. cohnii í tankmjólkursýninu. Sérlega áhugaverð er svo sú staðreynd að það var mun minna um Staf. simulans, Staf. haemolyticus og Staf. cohnii á kúabúum sem skoluðu alltaf mjólkurhylkin með heitu vatni eða gufu eftir að búið var að mjólka frumuháa kú. Þá lækkaði hlutfall af öllum undirhópum á þeim búum þar sem þeir sem mjólkuðu notuðu hanska við mjaltir.
KNS-bakteríur eru sakleysislegar þegar þær sjást á ræktunarskálum.
Mismunandi uppeldisstaðir KNS
Í hnotskurn draga höfundar vísindagreinarinnar þetta saman og draga þá ályktun að Staf. equorum og Staf. cohnii séu KNS bakteríur sem eiga rætur að rekja til umhverfisins og Staf. simulans komi innan frá júgrinu.
Höfundarnir benda þó á að rannsaka þurfi frekar KNS bakteríurnar svo hægt sé að gera sérstaka aðgerðaráætlun gegn einstökum undirhópum. Þá þurfi að fá betri greiningaraðferðir en nú eru algengar til þess að greina þessa undirhópa. Þannig eru t.d. flestar PCR greiningar á mjólk það einfaldar að í dag gefa niðurstöðurnar einungis til kynna að KNS hafi fundist í sýninu og í hve miklu magni, en segja ekkert um það hvaða undirflokkur KNS hafi verið á ferðinni. Þetta stendur þó til bóta í náinni framtíð með aukinni þekkingu á sýklum og enn bættri tækni við PCR greiningar.
Ekki gera ekki neitt
Allt of oft heyrist af kúabændum sem hafi nánast gefist upp á því að ná tankfrumutölunni niður fyrir 150.000/ml og trúa hreinlega ekki á það að hún geti farið undir 150.000/ml.
Þessi skoðun er e.t.v. enn algengari á kúabúum þar sem fáar kýr eru með sýnileg einkenni júgurbólgu og þar með með hærra hlutfall af dulinni júgurbólgu og líklega því með hátt hlutfall KNS sýkla.
Með stóraukinni þekkingu á smitleiðum einstakra sýkla, hvernig þeir lifa af í umhverfinu eða á og í kúnum og með stórbættum greiningaraðferðum er í dag miklu auðveldara en það var fyrir aðeins nokkrum árum, að setja upp raunhæfa áætlun sem miðar að því að ná tökum á ástandinu. Þá þarf viljinn líka að vera til staðar hjá kúabóndanum sjálfum og sérstaklega vegna þess að oft þarf að breyta einhverju í vinnubrögðum á búinu.
Snorri Sigurðsson
sns@seges.dk
Sviðsstjóri mjólkurgæðasviðs
Dýralækninga- og gæðadeild SEGES í Danmörku
